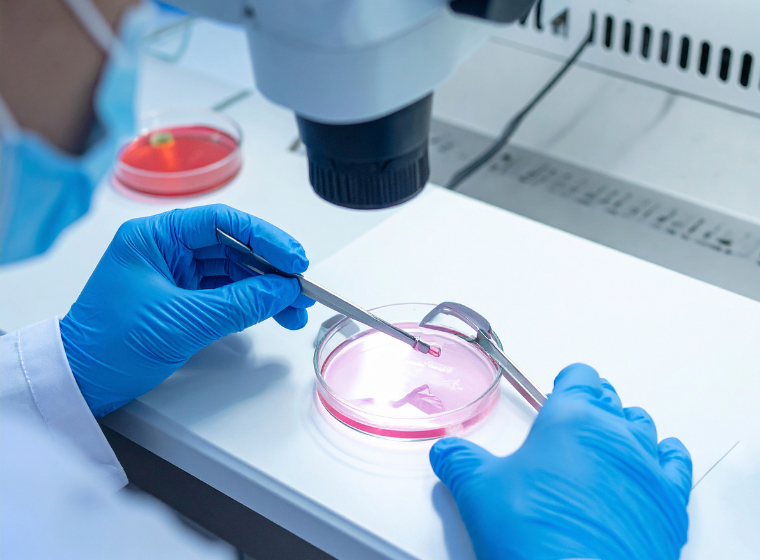
تجميد البويضات ونقل الأجنة

أصبح الحفاظ على الخصوبة خيارًا مهمًا للكثيرين ممن يرغبون في التخطيط للحمل وفقًا لشروطهم الخاصة. بفضل الطب الحديث، يمكن للنساء والأزواج تأجيل الحمل دون فقدان فرصة الإنجاب لاحقًا. من أكثر الطرق شيوعًا تجميد البويضات ونقل الأجنة. يزداد الإقبال على هذه العلاجات في تركيا، حيث تجعل العيادات المتقدمة والمتخصصون ذوو الخبرة العملية آمنة، وبأسعار معقولة، وناجحة.
تجميد بويضات المرأة يسمح بتخزينها لاستخدامها لاحقًا. ويُطلق عليه أيضًا تجميد البويضات. يُعد هذا الإجراء مفيدًا بشكل خاص للنساء اللواتي قد لا يكنّ مستعدات لتكوين أسرة لأسباب شخصية أو مهنية أو طبية. تبدأ العملية بتحفيز هرموني، مما يسمح للمبايض بإنتاج بويضات متعددة. بعد عملية جراحية سريعة، تُجمع هذه البويضات وتُجمّد بسرعة باستخدام عملية تُعرف باسم التزجيج. تمنع هذه التقنية التلف أثناء التخزين، مما يسمح للبويضات بالبقاء قابلة للحياة لسنوات عديدة. يوفر تجميد البويضات راحة البال، ويمنح النساء مزيدًا من المرونة والحرية في التخطيط لمستقبلهن.
يقوم تجميد البويضات بتخزين البويضات غير المخصبة، في حين يعد نقل الأجنة ضروريًا في عملية التلقيح الصناعي، حيث يتم وضع الأجنة المخصبة في الرحم لتحقيق الحمل.
الخطوات واضحة:
غالبًا ما يُنظر إلى نقل الأجنة على أنه المرحلة الأكثر تفاؤلًا في التلقيح الصناعي، إذ يُقرّب احتمالية الحمل. يلجأ العديد من الأزواج الذين يعانون من العقم إلى هذه الطريقة عندما يتعذّر عليهم الحمل الطبيعي.
قد يتساءل بعض النساء والأزواج عن الخيار الأفضل: تجميد البويضات أم الأجنة؟ يُتيح تجميد البويضات استقلالية أكبر، إذ لا يتطلب استخدام الحيوانات المنوية أثناء الحفظ. من ناحية أخرى، قد يُحقق تجميد الأجنة، حيث تُخصب البويضات قبل التجميد، نسب نجاح أعلى قليلاً أثناء عملية الزرع. يعتمد الاختيار الصحيح على الظروف الشخصية، والعمر، والحالة الاجتماعية، والخلفية الطبية. غالبًا ما يُرشد أخصائيو الخصوبة في تركيا المرضى خلال هذه القرارات، لضمان توافق الخيار المُختار مع احتياجاتهم الطبية وأهدافهم الشخصية.
تُعرف تركيا الآن عالميًا كمركز لعلاج العقم. وهناك عدة عوامل تجعلها خيارًا جذابًا للمرضى الدوليين:
لقد جعل هذا الجمع بين الجودة والقدرة على تحمل التكاليف تركيا واحدة من الوجهات الأكثر ثقة لتجميد البويضات ونقل الأجنة.
يُعدّ التوازن بين السعر والجودة أحد العوامل الرئيسية المؤثرة على قرار المريضة بزيارة تركيا. في العديد من أنحاء العالم، قد تكون علاجات الخصوبة باهظة الثمن. أما في تركيا، فتكاليفها أقل بكثير، حتى مع إضافة تكاليف السفر. تشمل تكاليف تجميد البويضات عادةً تحفيز المبيض، واسترجاع البويضات، ورسوم التخزين. غالبًا ما تكون تكاليف نقل الأجنة جزءًا من باقات علاج التلقيح الصناعي. عادةً ما يوفر المرضى مبالغ كبيرة مقارنةً بالدول الأخرى مع استمرار حصولهم على رعاية صحية متميزة، مع اختلاف التكاليف باختلاف المنشأة وعدد الدورات المطلوبة.
قرار تجميد البويضات أو نقل الأجنة قرار شخصي للغاية. بالنسبة للكثيرين، يُخفف هذا القرار من ضغط ما يُسمى "الساعة البيولوجية". يمكن للنساء غير المستعدات للأمومة تجميد بويضاتهن بثقة. غالبًا ما يجد الأزواج الذين يعانون من العقم الأمل من خلال نقل الأجنة، حيث يختبرون فرحة الحمل بعد سنوات من التحديات. هذه العلاجات ليست مجرد إجراءات طبية، بل تُمثل الحرية والتحكم والطمأنينة بشأن المستقبل.
يمكن للمرضى الدوليين القادمين إلى تركيا لتلقي علاجات الخصوبة توقع إجراءات سلسة. تبدأ العيادات عادةً باستشارة وتقييم للخصوبة. بعد تقييم الحالة الصحية والأهداف، يضع الأطباء خطة علاجية شخصية. خلال فترة العلاج، يتلقى المرضى مراقبة طبية دقيقة، ومرافق مريحة، ورعاية داعمة. كما تقدم العديد من العيادات خدمات الترجمة ومساعدة للمرضى الدوليين لجعل تجربة العلاج مريحة قدر الإمكان.
منح تجميد البويضات ونقل الأجنة أملًا جديدًا لمن يرغبن في الحفاظ على خصوبتهن أو التغلب على العقم. تتيح هذه العلاجات للعائلات التخطيط لمستقبلهم بثقة. برزت تركيا كوجهة رائدة لهذه العمليات بفضل معداتها الطبية المتطورة، وكوادرها الطبية المؤهلة، وأسعارها المعقولة. سواءً كان الهدف هو الحفاظ على الخصوبة أو الحمل، فإن اختيار تجميد البويضات ونقل الأجنة في تركيا قد يكون خطوةً حاسمةً نحو الأبوة.